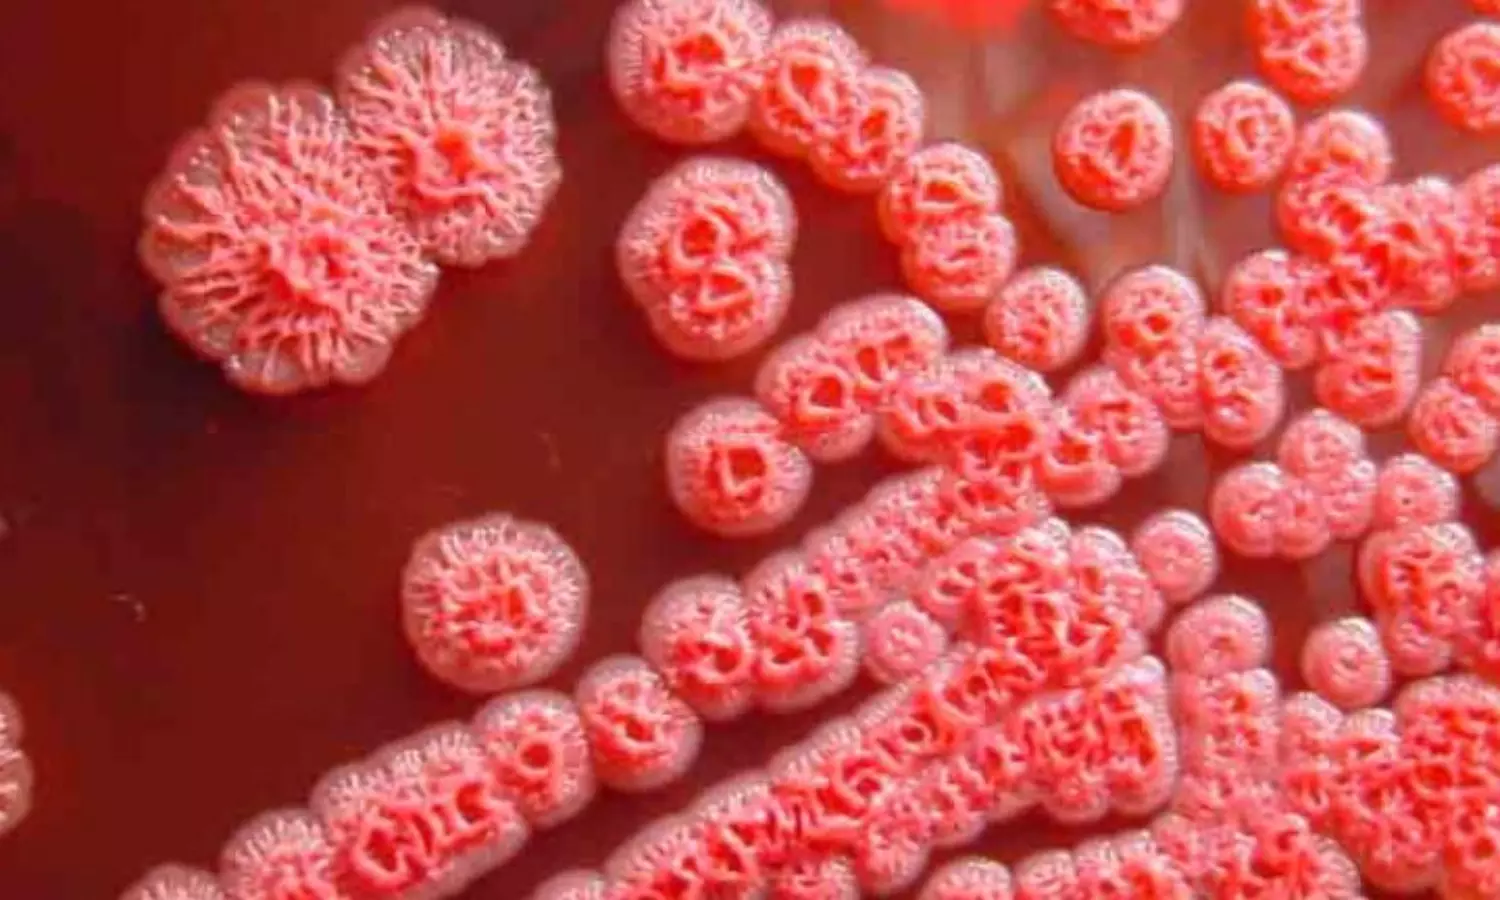
US authorities monitoring a dangerous bacteria found in Gulf Coast

ARCHIVE SiteMap 2023-06-07
 Kolhapur police cane-charge Hindutva protestors demanding action on social media posts
Kolhapur police cane-charge Hindutva protestors demanding action on social media posts Criticism mounts as BJP stands with UP MP accused of misconduct and threats
Criticism mounts as BJP stands with UP MP accused of misconduct and threats Amid reports of Indian economy booming, experts point at symptoms of slowdown
Amid reports of Indian economy booming, experts point at symptoms of slowdown Tom Holland claims "The Crowded Room" made him take an extended break
Tom Holland claims "The Crowded Room" made him take an extended break Diabetes drug Ozempic takes China by storm, touted as miracle weight loss drug
Diabetes drug Ozempic takes China by storm, touted as miracle weight loss drug US authorities monitoring a dangerous bacteria found in Gulf Coast
US authorities monitoring a dangerous bacteria found in Gulf Coast Ashish Vidyarthi said "was shocked" on being trolled for getting married at 57
Ashish Vidyarthi said "was shocked" on being trolled for getting married at 57 Unfamiliar food, language issues: stranded Air India passengers in Russia recount suffering
Unfamiliar food, language issues: stranded Air India passengers in Russia recount suffering K'taka to drop lessons on RSS founder Keshav Baliram Hedgewar from school syllabus
K'taka to drop lessons on RSS founder Keshav Baliram Hedgewar from school syllabus Cong, BJP slam Kerala CM Vijayan’s foreign trip amid financial crisis
Cong, BJP slam Kerala CM Vijayan’s foreign trip amid financial crisis Cong warns govt of having to pay hefty price for ‘protecting’ accused on wrestlers’ issue
Cong warns govt of having to pay hefty price for ‘protecting’ accused on wrestlers’ issue Manipur violence: Kuki community protesters gather outside Amit Shah's home
Manipur violence: Kuki community protesters gather outside Amit Shah's home